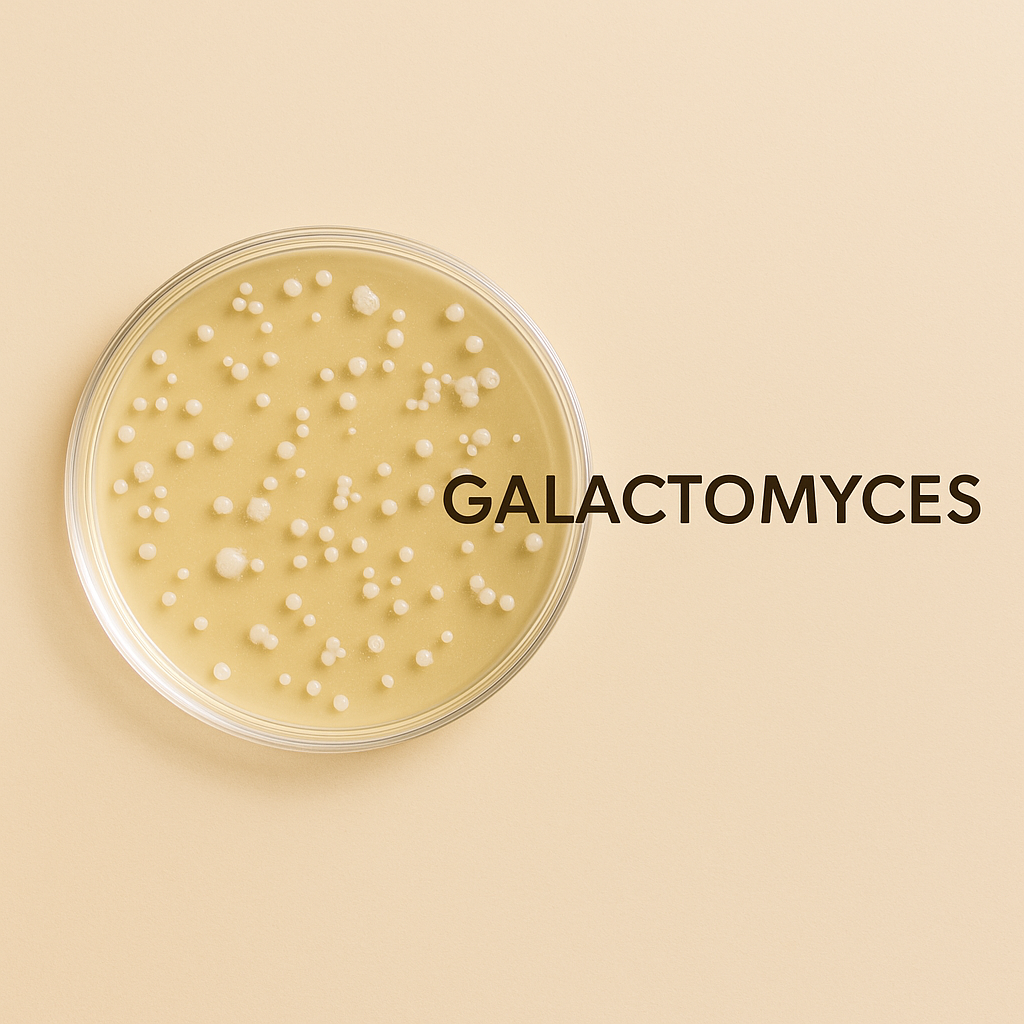

I'm 57 and have had redness on my cheeks and nose for as long as I can remember. Foundations either made it worse or felt like a mask. This one calmed everything down instantly. Wore it all day in Florida heat and it didn't move. My skin looked even and natural the entire time. Finally something that actually works for redness without feeling heavy.

Ok so I was really skeptical about this whole color changing thing but WOW. It went on white and literally turned into my shade. My skin looks so smooth and natural, not cakey at all. I have combo skin and this is the first foundation that doesn't get oily on my t-zone or cling to dry patches on my cheeks. Already on my second bottle.

Wore this to dinner and got three compliments on my skin. THREE. At 62 that doesn't happen often lol. The coverage is perfect, hides my dark spots but still looks like real skin. And it's fragrance free which my sensitive skin desperately needs. Love love love it.
Magic Skin Changing Foundation
Magic Skin Changing Foundation
⏱️ Flawless base in 2 minutes
🌸 Perfect for Mature & Sensitive Skin
✨ No cakey or settling in lines
Couldn't load pickup availability
Magic Skin Changing Foundation
Try this product risk-free. No match? 100% money back!
30 day money back guarantee
30 day money back guarantee
At VIMA, we give you the assurance of a perfect color match with our Magic Skin Changing Foundation. You can try it out with complete confidence and without any risk. If the foundation does not blend seamlessly with your skin tone, you are entitled to a full money-back guarantee – quick, easy, and effortless.
Why mature skin loves this
Why mature skin loves this
This foundation was made for real skin, not airbrushed models. It's ultra-lightweight, feels like second skin, and adapts to your exact undertone within seconds.
No cakey finish. No heavy mask feeling.
Just smooth, even skin that looks naturally radiant every day.
✓ Covers redness & dark spots (even under the eyes)
✓ Floats over fine lines instead of settling into them
✓ Evens out your complexion in seconds
✓ Fragrance-free, gentle on sensitive & mature skin
✓ SPF 30 built in, one less step in your routine
How does it work?
How does it work?
Struggle with foundations that turn orange, leave you pale or feel heavy? The VIMA Magic Skin Changing Foundation adapts to your unique skin tone with innovative color-matching technology, blending with your skin’s warmth and pH for lightweight, buildable coverage that always looks natural.
Does it work on my skin?
Does it work on my skin?

How to use?
How to use?
Step 1: Apply a small amount of foundation with the VIMA 2-in-1 brush or your fingers. Start light so you can find the perfect amount for your look.
Step 2: Let the foundation rest briefly so it adapts perfectly to your skin tone and pH. For more coverage, simply build it up — the formula is lightweight and buildable.
Step 3: Enjoy a smooth, natural-looking finish that feels like your own skin.
Ask a question
Ask a question
Click here and ask us a question!
We will respond as soon as possible.























Powered by Skin-Loving Ingredients
A foundation enriched with active skincare ingredients that hydrates, protects, soothes and fights aging while giving flawless coverage, helping to fade dark spots, smooth lines, calm redness and strengthen your skin.
VIMA vs Other Brands
Most foundations feel heavy, look cakey, settle into fine lines and don't match your skin tone. VIMA doesn't.

|
OTHERS | |
|---|---|---|
Adapts to your tone |
||
Also for mature skin |
||
No settling or cakey finish |
||
Covers redness and dark spots |
||
Evens skin tone and texture |
||
Gentle for sensitive, aging skin |
||
Lightweight, breathable wear |
||
Evens age spots & lines |
||
Sweat & waterproof |

Change Your Life With Our Changing Foundation
96%
Neutralizes redness and evens out skin tone
92%
Minimizes pores and smooths skin texture
98%
Hydrates and softens fine lines—without caking
97%
Natural, second-skin coverage that lasts all day
FREQUENTLY ASKED QUESTIONS
Is it suitable for mature skin?
Is it suitable for mature skin?
Yes, the VIMA Magic Skin Changing Foundation is perfect for mature skin. Its lightweight, hydrating formula smooths over fine lines and wrinkles, providing a natural and radiant finish without settling into creases. The buildable coverage allows you to achieve a flawless look while keeping your skin nourished and comfortable throughout the day.
How well does it cover?
How well does it cover?
The Magic Skin VIMA Changing Foundation offers buildable, light to medium coverage, but it can also provide full coverage depending on the amount you use. Redness, dark spots and uneven texture are visibly reduced while still looking natural. It easily adapts to your needs, giving you the freedom to create your perfect look.
Do I need a primer?
Do I need a primer?
It's not required, but we do recommend using a primer before applying the VIMA Magic Skin Changing Foundation for an even smoother finish. For best results, try our Magic Smooth Skin Primer.
Does it cover freckles?
Does it cover freckles?
Yes, the VIMA Magic Skin Changing Foundation covers freckles excellently! For areas with more pigmentation, we recommend combining the foundation with a concealer for extra coverage.
Is it suitable for wrinkles or fine lines?
Is it suitable for wrinkles or fine lines?
Absolutely! The VIMA Magic Skin Changing Foundation has a lightweight and hydrating formula designed to nourish and care for your skin. It’s an excellent choice for reducing the appearance of wrinkles and fine lines, while providing a natural and radiant look.
What’s the best way to apply it?
What’s the best way to apply it?
For the best results, we recommend applying the foundation with our 2-in-1 Brush. This brush helps the pigment particles penetrate deeper into the skin, preventing white streaks and ensuring a flawless finish.
Does it work for redness or rosacea?
Does it work for redness or rosacea?
Yes. The adaptive pigments instantly neutralize redness and even out the skin tone without irritation.
Will it look cakey during the day?
Will it look cakey during the day?
No. The formula stays lightweight and skin-like, even after hours of wear.
Will it look cakey during the day?
Will it look cakey during the day?
No. The formula stays lightweight and skin-like, even after hours of wear.
Is it good for sensitive skin?
Is it good for sensitive skin?
Yes. It is fragrance free and made with skin-loving ingredients like niacinamide and vitamin E, so it stays gentle on reactive skin.
Does it oxidize or turn orange?
Does it oxidize or turn orange?
No. The shade stays stable all day thanks to the color-adapting technology.
How long does it last?
How long does it last?
It stays fresh for up to 12 hours. For even longer wear, pair it with the All Day Glow Setting Spray.
Is it waterproof or sweat proof?
Is it waterproof or sweat proof?
Yes. It holds up in heat, humidity and long days without melting or smudging.
Will it clog my pores?
Will it clog my pores?
No. The formula is breathable, light and suitable for acne-prone skin.
Can I use it every day?
Can I use it every day?
Yes. It feels like a second skin and is gentle enough for daily use.
What if my skin tone changes with the seasons?
What if my skin tone changes with the seasons?
It adapts naturally, so it still matches perfectly in summer and winter.
Does it help with dull or tired skin?
Does it help with dull or tired skin?
Yes. It brightens the complexion and gives a natural glow.
Will it cover dark spots or uneven patches?
Will it cover dark spots or uneven patches?
Yes. The formula evens out discoloration without looking heavy.
Will it feel heavy on my skin?
Will it feel heavy on my skin?
No. It has a lightweight, serum-like texture that feels weightless.
Can I use it if I have dry skin?
Can I use it if I have dry skin?
Yes. It hydrates while covering and does not cling to dry patches.
Can I use it if I have oily skin?
Can I use it if I have oily skin?
Yes. It adapts to natural oils and keeps the finish balanced throughout the day.
Do I need to set it with powder?
Do I need to set it with powder?
You can if you want a matte finish. For a long-lasting natural glow, use the All Day Glow Setting Spray.